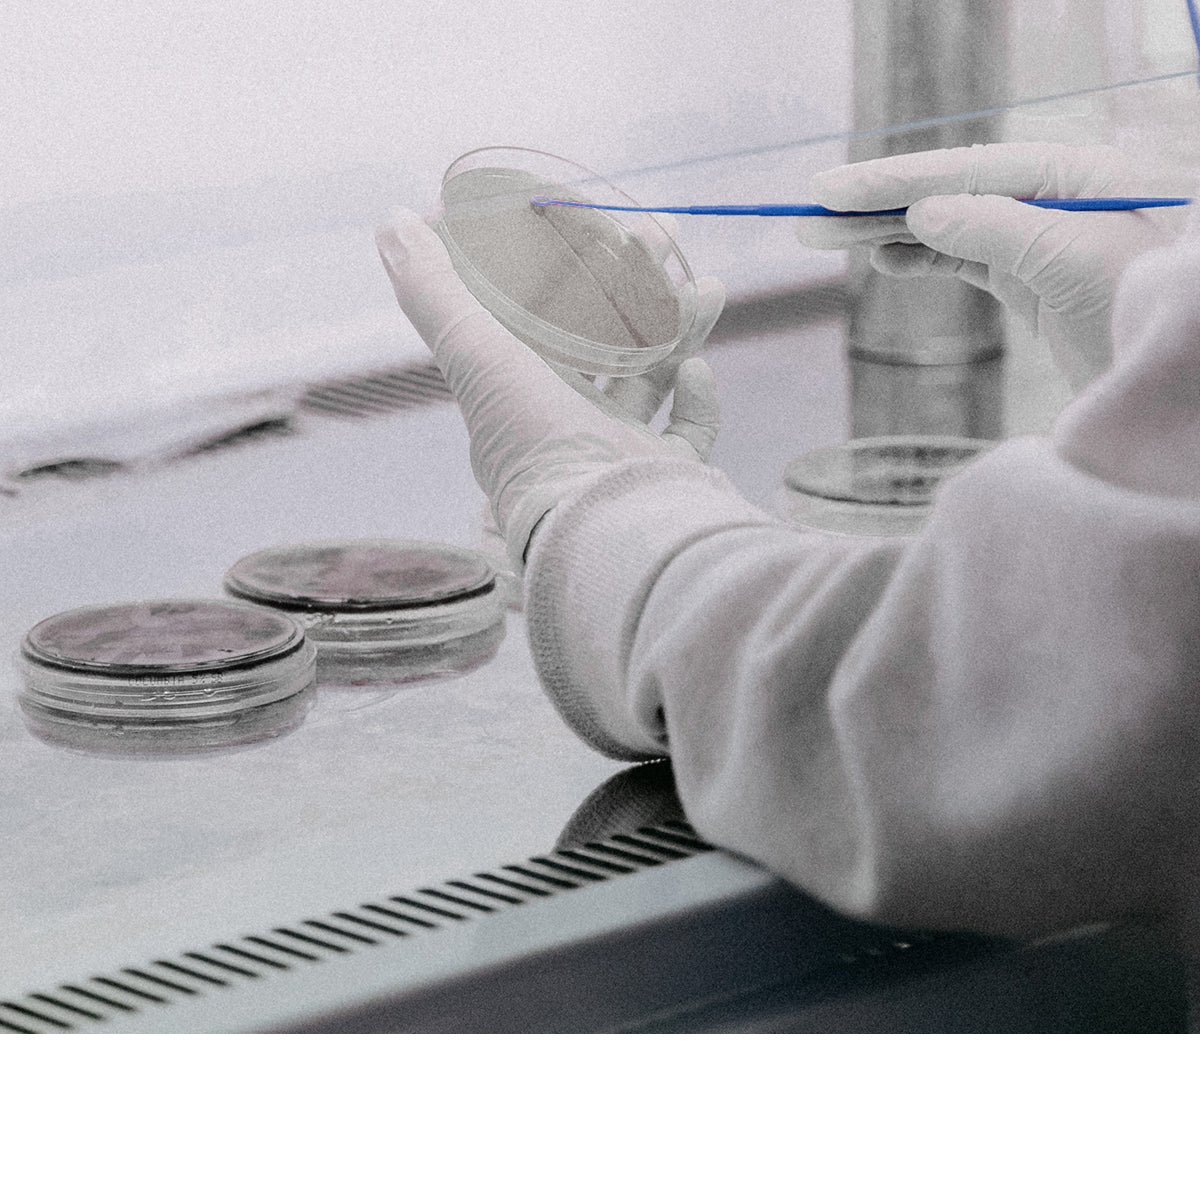
CELIV - Innovación en Dermocosmética directamente del sur de Chile

Muy contenta con mi micelar porque es un producto de muy buena calidad ya que ademas de dejar mi cara limpia queda muy hidratada , la recomendaria 100%
Excelentes productos, efectivos resultados de hidratación y mejoras de la piel, aporta vitalidad y firmeza. Este es mi 2do pack que compro. Muy buena calidad, los recomiendo 100%!
Me encanta este producto. He probado varios y me cuesta encontrar alguno que no me de alergia (en general me pican los ojos) y que al mismo tiempo me saque la cara de dormida. Me ayuda mucho a despertar la cara, me la revitaliza sin dejar brillo ni nada que se note. Es de los productos Celiv que me fascina y ya llevo un buen tiempo comprándolo. Además la atención es increíble!
Ha mejorado la humectación del contorno de ojos, el aspecto de cansancio también, así como las arrugas más finas
Exquisita, muy hidratante, liviana como una nube, me encantó